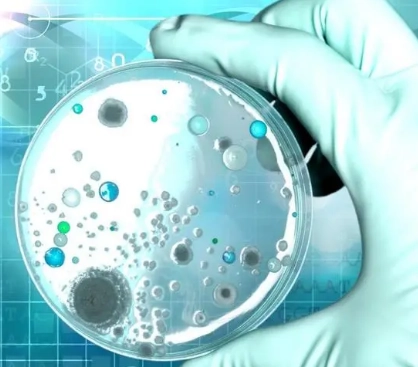

科学探索的巅峰之作:令人震惊的实验
复制2024-11-12 12:04:47
98
科学实验是推动人类知识进步的重要手段,历史上有许多实验因其惊人的结果而名声大噪。这些实验不仅在科学界产生了深远的影响,也让我们对这个宇宙和我们自己的本质有了新的认识。以下是一些令人震惊的科学实验,它们展示了科学探索的辉煌成就。
挑战极限的物理学实验
物理学领域有一个著名的实验叫做“量子隧穿实验”,它证实了量子力学中粒子可以穿越看似不可逾越的障碍的现象。这个实验不仅令人难以置信,而且为发展现代电子学、量子计算等领域奠定了基础。
化学领域的奇异转化
在化学领域,门捷列夫的元素周期表实验通过将元素按照其原子质量进行排列,揭示了元素的周期性规律,这一发现极大地推动了化学元素的系统研究,并指导了后续的许多化学反应实验。
生物学上的突破性进展
生物学领域的“克隆羊多莉”实验首次证明了成熟动物细胞核移植技术的可行性。这一实验不仅引发了伦理和哲学上的广泛讨论,也为组织再生和生物医学研究提供了新的视角。
心理学的里程碑实验
斯坦福监狱实验是一个模拟监狱环境以研究人在特定社会角色下的心理变化的经典心理学实验。尽管该实验因伦理问题而饱受争议,但它为理解权力、权威与人类行为的关系提供了宝贵的洞察。
天文学的跨越性观测
天文学上,霍金辐射的理论预言及间接验证实验向我们揭示了黑洞不是完全黑的,它们也会辐射出粒子。这一发现挑战了传统的物理学理论,为我们理解宇宙最极端的环境提供了新的窗口。
结语:
这些惊人的科学实验代表了人类对未知世界的好奇心和探索精神。它们不仅推动了科学的边界,也让我们对自然规律和人类社会有了更深刻的认识。每一个成功的实验都是对既有知识的挑战,也是对未来无限可能的期待。科学实验的惊人之处不仅在于结果,更在于它们激励着无数人继续探索未知,不断进步。
免责声明:以上内容源自网络,版权归原作者所有,如有侵犯您的原创版权请告知,我们将尽快删除相关内容。